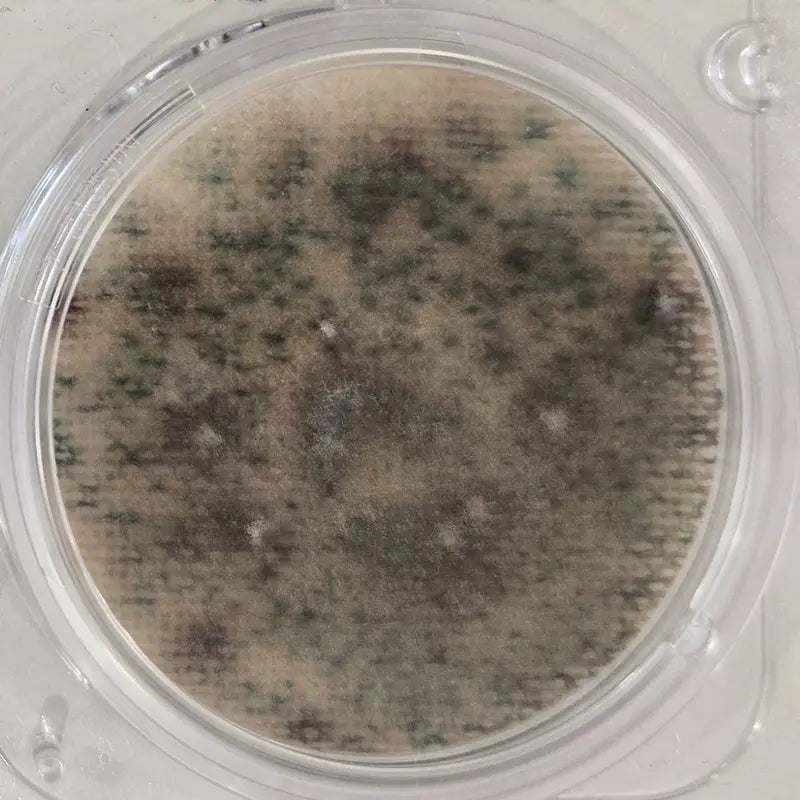
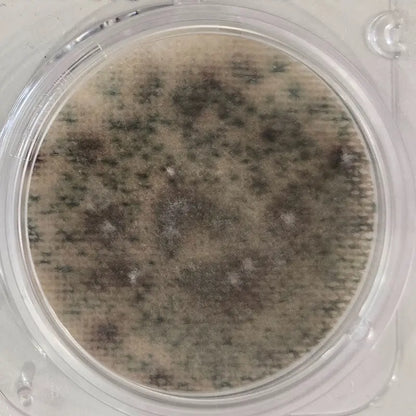

Indoor Air Quality Test Kit for home
Indoor Air Quality Test Kit for home
Couldn't load pickup availability
 
add_shopping_cart
-
Ordered
local_shipping
- - -
Order Ready
redeem
- - -
Delivered
Indoor Air Quality Test Kit for home
Regular price
$34.99
Regular price
$34.99
Sale price
$69.99
Unit price
/
per
Description
The Indoor Air Quality Test Kit gives you fast, reliable insights into your home's air health. Designed for easy at-home use, it detects airborne mold spores and other pollutants—making it perfect for post-remediation checks or routine indoor air snapshots. Get lab-quality results without the hassle, so you can breathe easier and make informed decisions to keep your space safe and healthy.